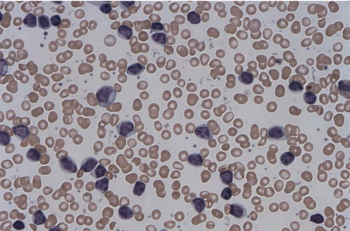

Highlights of breast cancer advances at the ESMO Congress.

Your AI-Trained Oncology Knowledge Connection!


Highlights of breast cancer advances at the ESMO Congress.

Five notable abstracts from the 2019 World Conference on Lung Cancer (WCLC).

A rare occurrence, cancer in the esophagus requires an individualized treatment plan.

Burnout is defined as an occupational-related syndrome characterized by physical and emotional exhaustion, cynicism/depersonalization, and low sense of professional accomplishment.

ONCOLOGY recently spoke with Dr. Sandip Patel about a potential novel therapeutic ap- proach to treating patients with neuroendocrine tumors.

Geriatric assessments have now been recommended as part of the standard evaluation of an older adult considering cancer therapy.
The treatment landscape for chronic lymphocytic leukemia has dramatically changed in the past decade.